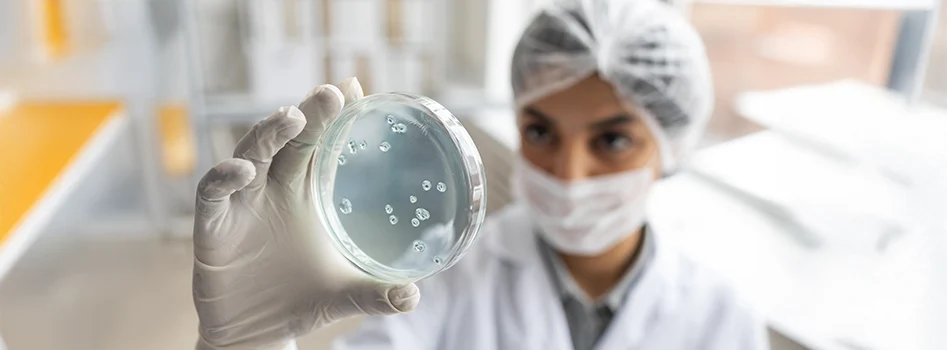

In the IVF laboratory, oocyte quality remains one of the most crucial aspects that goes into determining the success of an IVF treatment.
Mitochondria, which are the structures inside the egg that produce the energy required to promote egg maturity, fertilization, and early embryo development. Research studies show that mitochondrial function extends beyond supplying energy, as it influences chromosomal stability, cellular balance, and overall developmental potential.
For embryologists, understanding mitochondrial function is essential to improving outcomes in ART. So, if you are planning your career in embryology or are curious about the latest research, keep reading this blog, as we dive into the mitochondrial function in oocytes and its impact.
The role of mitochondria as central regulators of oocyte function
Mitochondria are the main source of energy molecules in the oocyte. This energy is required for important steps, such as spindle formation, chromosome alignment, and cytoplasmic maturation. According to the research published in Biology of Reproduction and Human Reproduction Update, a low amount of ATP can impact the spindle formation. This can further increase the chromosomal errors.
When it comes to fertilization, mitochondria keep calcium signals under control, which are crucial for oocyte activation after fertilization. In the early stages of embryo development, the embryo is mainly dependent on the mitochondria that are present in the egg. Since mitochondria are not produced immediately, various aspects such as their number, placement, and health in the mature oocyte cycle strongly influence fertilization as well as embryo development.
Significance of mtDNA copy number and development
To know the functionalities of mitochondria, let’s first dive into what the mtDNA is all about. The Mitochondrial DNA, also known as the mtDNA, refers to the genetic material within mitochondria.
During oocyte growth, the number of mtDNA copies multiplies over thousands to reach the early needs of fertilization and support early embryo growth in an effective manner. The low mtDNA levels are often found in oocytes that lack developmental potential, which proves that the mtDNA amount influences oocyte quality and developmental competence.
Impact of mitochondrial dysfunction on oocyte quality
Mitochondrial dysfunction in oocytes takes place when the egg’s mitochondria are unable to produce energy or maintain normal oocyte activity. This impacts embryo development by slowing down the maturation, which ultimately affects fertilization. Now, the causes of mitochondrial dysfunction are plenty, such as low ATP production, disrupted calcium balance, mtDNA mutations, excessive ROS, and so on.
So how does it impact oocyte quality? These look like impaired spindle formation and abnormal chromosomal alignment, lowering the fertilization rates and affecting embryo development. ROS or excess reactive oxygen species and oxidative damage further weaken cellular structures and DNA. As a result, the oocyte does not mature properly and loses quality. This also affects the fertilization and implantation success rates in both natural conception and IVF cycles.
How does age affect mitochondrial function in oocytes?
You already know that women’s fertility declines with age as the number of eggs and their quality drop. This is because the mitochondria in the oocytes become less active in producing ATP for effective maturation and embryo development.
In older women, the mitochondrial structure is mostly damaged, and the oocytes have a higher chance of mitochondrial dysfunction. Also, oxidative stress is generally higher in older eggs, which affects the mitochondrial components and working mechanism. Thus, oocyte quality reduces, and so does the conception rate.
Oxidative Stress: From Mechanism to Modifiable Risk
When the ROS (reactive oxygen species) builds up faster than the oocyte’s antioxidant defense system gets activated, oxidative stress occurs. During energy or ATP production, mitochondria naturally produce ROS, and when it goes up to an excess level, as a result of aging, environmental factors, or lab conditions, the mitochondrial membranes and enzymes that are crucial for energy or ATP production get damaged. The oocytes are then unable to perform their functionalities, which raises the risk of chromosomal errors and reduces the egg’s ability to grow into a healthy embryo.
What does this mean for IVF labs today?
Now that you know how mitochondrial dysfunction disrupts oocyte quality and fertilization, embryologists these days are expected to make informed decisions by staying up to date with the new findings in the industry to effectively improve IVF outcomes. Here are some of the lab practices that can be applied by embryologists:
- Minimize oxidative stress: Ensure that there is proper temperature control, minimal handling, and optimal culture conditions. This helps restrict excess ROS and protects mitochondrial functions for increased fertility.
- Assess metabolic activity with morphology: Evaluate mitochondrial activity, energy metabolism in oocytes, and oxygen consumption. This gives you precise insights into the potential of embryo development.
- Monitor oocyte mitochondrial health: Embryologists must ensure that eggs have sufficient and well-functioning mitochondria to prevent low energy production and related dysfunction.
- Apply research-proven strategies: According to studies published by MDPI, optimal oxygen levels in culture can improve mitochondrial health, as long as the necessary protocols are verified.
Conclusion
For the success of natural fertilization or IVF procedures, mitochondrial health plays a major role and inevitably influences the healthy development of the embryo. As an embryologist, it is important to look out for the emerging research highlights to understand how mitochondrial function can be improved to maintain oocyte quality. Embryologists can make use of these insights to increase IVF success rates.
If clinical embryology excites you, explore assited reproductive technology and reproductive sciences at MOMSOON Academy. Our clinical embryology programmes give you in-depth guidance and industry exposure!